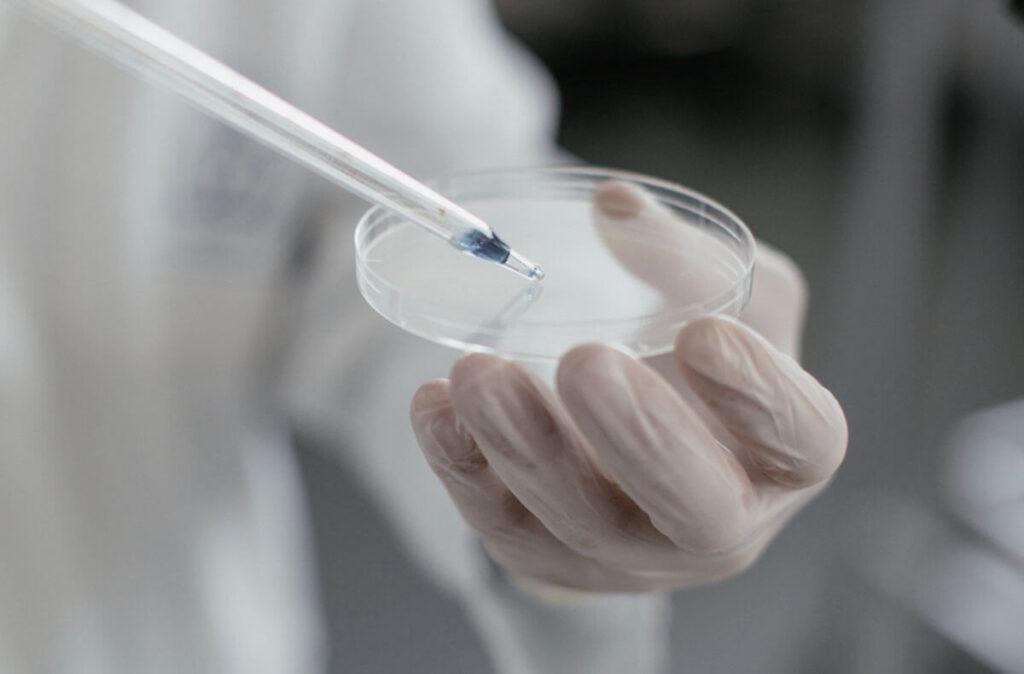

De Luca & Partners lavora a stretto contatto anche con numerosi studi legali d’affari, società di private equity e fondi di investimento con i quali è tipicamente coinvolto nella gestione degli aspetti del diritto del lavoro nell’ambito di operazioni di Mergers and Acquisitions (M&A) e/o di ristrutturazione aziendale.
De Luca & Partners, nell’ambito delle operazioni di M&A e ristrutturazione, si occupa dell’attività di due diligence giuslavoristica.
L’attività di due diligence consiste in un’approfondita indagine di ogni profilo giuslavoristico dell’attività di impresa, finalizzata a verificare il rispetto da parte di una società della normativa in materia di lavoro.
In particolare, il lavoro di due diligence ha come scopo primario quello di fornire una descrizione di eventuali criticità – connesse con i profili relativi al diritto del lavoro e concernenti il personale in forza della società target – potenzialmente rilevanti ai fini dell’operazione. L’indagine si orienta, principalmente, a verificare il rispetto delle norme imperative di legge applicabili, dei contratti collettivi e degli eventuali accordi integrativi aziendali.
Tale attività di due diligence si riferisce non soltanto ai rapporti di lavoro subordinato ma anche a ogni altra tipologia di rapporto contrattuale di diversa natura concernente i soggetti che svolgono la propria opera in favore della società in modo continuativo e organico (tra cui lavoratori autonomi, collaboratori occasionali, agenti, prestatori d’opera o di servizi). Particolare attenzione è rivolta, inoltre, all’analisi delle figure che rivestono un ruolo strategico nell’organizzazione aziendale e beneficiano di una remunerazione cospicua (c.d. key managers), e che quindi in caso di irregolarità potrebbero avere un notevole peso nelle negoziazioni.
In ciascuno degli ambiti sopra indicati, il dettaglio dell’analisi arriverà sino alla disamina di aspetti quali anzianità di servizio, trattamento economico complessivo (inclusi stipendio fisso, bonus percepiti e fringe benefit riconosciuti), costo azienda, partecipazione a piani pensionistici, accordi di non concorrenza, coperture assicurative, lavoro straordinario, procedimenti disciplinari.